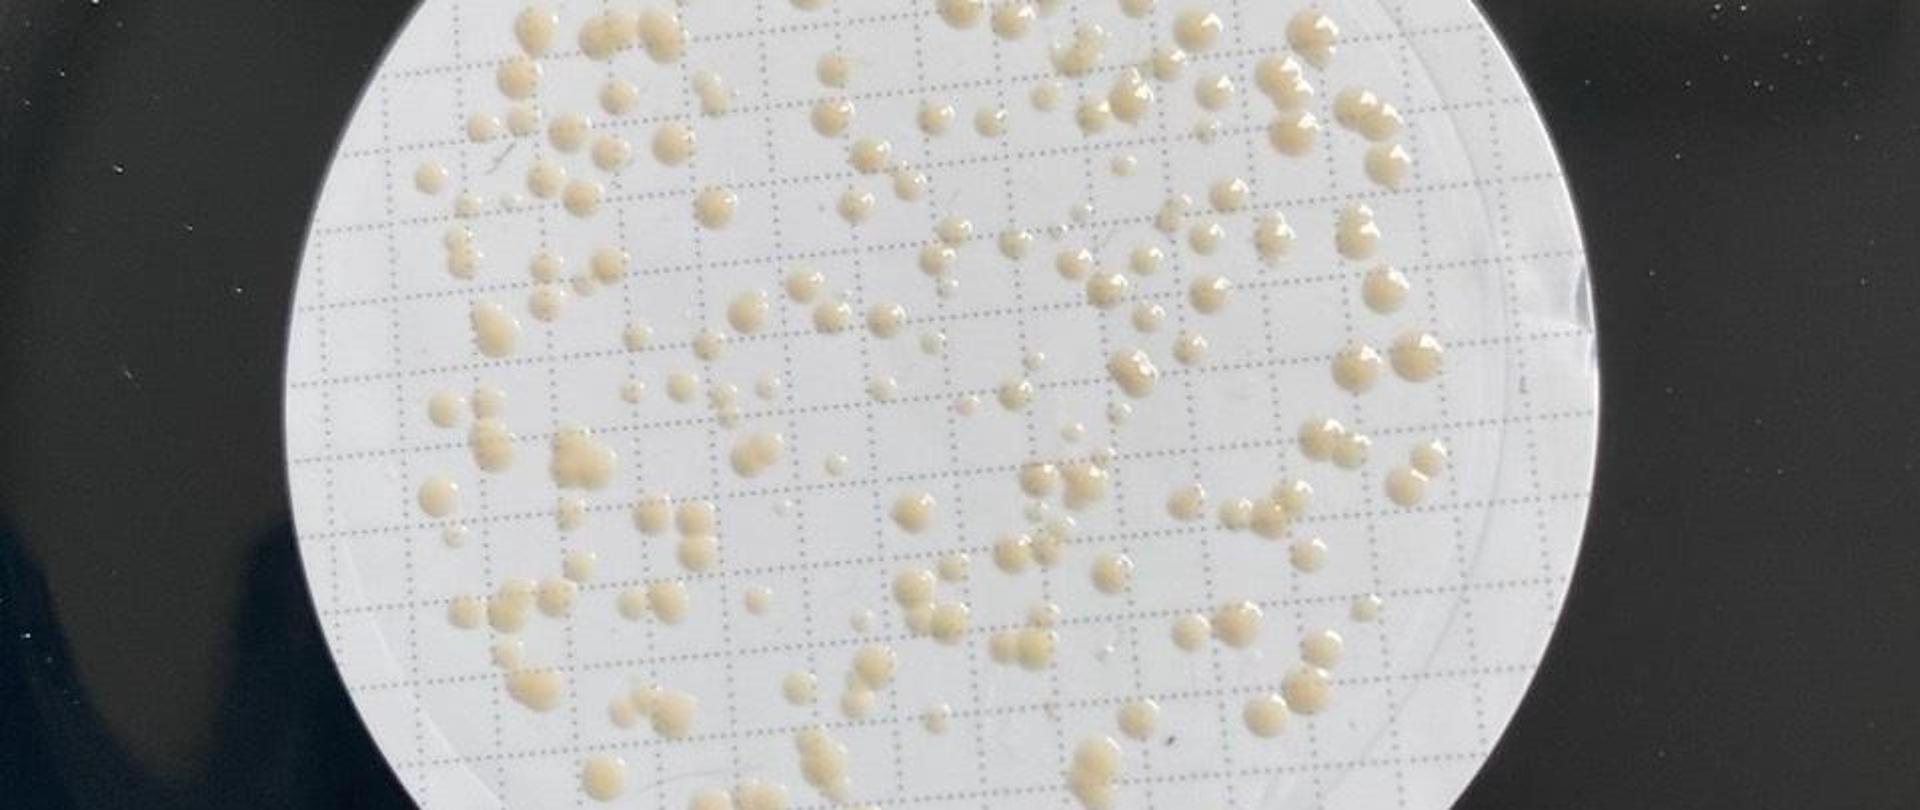
bakteria_legionella

Legioneloza - Informacja w związku z sezonem wakacyjnym
06.08.2024
LEGIONELOZA - choroba zakaźna wywoływana przez bakterie z rodzaju Legionella.
Występowanie
Bakterie Legionella występują na całym świecie i są szeroko rozpowszechnione w środowisku. Rezerwuarem są płynące i stojące wody powierzchniowe, śródlądowe i gruntowe, ścieki, kałuże po opadach deszczu, mokra gleba, kompost czy rozkładająca się kora i trociny.
Bakterie wykrywane są też w składzie biofilmu tworzącego się na powierzchniach kontaktujących się z wodą - w sprzyjających warunkach mogą przedostawać się z naturalnych źródeł za pomocą sieci wodociągowej i w wyniku namnażania kolonizować sztuczne rezerwuary wodne,
a także zasiedlać kolejne instalacje, urządzenia i systemy, jak:
- systemy dystrybucji wody ciepłej użytkowej (np. w hotelach, miejscach zamieszkania zbiorowego, szpitalach),
- aparatura wykorzystywana w podmiotach leczniczych (np. respiratory, inhalatory, nawilżacze powietrza),
- obiekty rekreacji wodnej (np. baseny, fontanny, zraszacze ogrodowe),
- wieże chłodnicze, klimatyzatory,
- myjnie samochodowe, spryskiwacze samochodowe itd.
Aby proces zasiedlania instalacji bakteriami nastąpił muszą wystąpić warunki sprzyjające tj. np. niewłaściwie utrzymywane, eksploatowane systemy.
Optymalna temperatura wzrostu bakterii Legionella to 20-50°C
Ze względu na ww. właściwości bakterii Legionella w miesiącach letnich często obserwowany jest wzrost liczby zakażeń u ludzi. Szczyt zachorowań przypada w okresie letnim (zwykle od czerwca do września), co jest ściśle związane zarówno z warunkami pogodowymi (wzrost temperatury i wilgotności powietrza), jak również intensyfikacją turystyki i rekreacji.
Głównym źródłem zakażenia jest woda zaciągnięta do układu oddechowego lub zainhalowana w postaci aerozolu wodno-powietrznego zawierającego bakterie z rodzaju Legionella. Aerozol wodno-powietrzny bywa wytwarzany przez urządzenia sanitarne (np. prysznice), medyczne (np. unity stomatologiczne, respiratory), rekreacyjne (urządzenia instalowane na basenach, wanny z hydromasażem), klimatyzację, czy też urządzenia takie jak fontanny, zraszacze lub kurtyny wodne. Nie stwierdzono dotychczas przypadku zakażenia się od człowieka do człowieka.
Zakażenie
Możesz zachorować na legionelozę, jeśli:
- będziesz narażony na inhalację aerozolu zawierającego bakterię,
- zachłyśniesz się skażoną wodą.
- Zakaźny jest aerozol wytwarzany przez urządzenia sanitarne, rekreacyjne, fontanny, nawilżacze, klimatyzacje, wieże chłodnicze itp., które są niewłaściwie serwisowane, niedokładnie czyszczone lub włączone do użytkowania po wydłużonym przestoju lub ograniczonej eksploatacji bez wdrożenia odpowiednich działań zapobiegających namnażaniu bakterii z rodzaju Legionella.
- Nie odnotowano zakażenia ludzi w wyniku picia skażonej Legionella wody.
- Nie odnotowano zakażenia się człowieka od innej chorej osoby (choroba niezaraźliwa).
Wyróżnia się trzy postacie kliniczne choroby, a okres wylęgania (od momentu zakażenia do czasu pojawienia się pierwszych objawów) trwa od 2 do 10 dni:
- choroba legionistów - postać najczęściej rozpoznawana, z dominującymi objawami zapalenia płuc o ciężkim przebiegu, często z towarzyszącymi objawami uszkodzenia wielu narządów (bóle mięśni, ból głowy, gorączka, objawy zapalenia płuc w tym suchy kaszel, zaburzenia oddychania, zaburzenia ze strony przewodu pokarmowego, w tym bóle brzucha, wymioty, biegunka, a także zaburzenia świadomości);
- gorączka Pontiac - postać pozapłucna łagodna, różne postacie zakażenia umiejscowionego poza płucami charakteryzujące się lżejszym przebiegiem i objawami przypominającymi zachorowanie na grypę (nagły wzrost temperatury ciała, ból głowy, mięśni, dreszcze, objawy zakażenia górnych dróg oddechowych). Wyzdrowienie następuje samoistnie po kilku dniach, osoby zakażone nie wymagają leczenia;
- postać pozapłucna ciężka - przebiega z zakażeniem uogólnionym, któremu może towarzyszyć stan septyczny.
Do grupy szczególnego ryzyka zalicza się:
- osoby po 50 r.ż.,
- palenie papierosów,
- alkoholizm,
- współistniejące choroby przewlekłe,
- choroby nowotworowe,
- transplantacje,
- płeć męską.
Leczenie i diagnostyka
W większości przypadków legioneloza jest wyleczalna przy użyciu antybiotyków. Do zgonów najczęściej dochodzi u osób starszych i u osób z obniżoną odpornością.
Zakażenie można rozpoznać tylko poprzez wykonanie badań laboratoryjnych. Preferowanymi testami diagnostycznymi są posiew wydzieliny z dróg oddechowych albo test na obecność antygenu Legionella w moczu.
Niezmiernie ważne jest, aby materiał do badań pobrać przed wdrożeniem antybiotykoterapii, ponieważ zastosowanie antybiotyków przed pobraniem od pacjenta materiału do badań może uniemożliwić wykonanie badania.
Więcej informacji
- https://epibaza.pzh.gov.pl/story/legioneloza
- https://www.ecdc.europa.eu/en/legionnaires-disease
- https://www.cdc.gov/investigate-legionella/index.html
- https://www.gov.pl/web/gis/dzialania-panstwowej-inspekcji-sanitarnej-w-zwiazku-z-wystapieniem-przypadkow-legionelozy
- https://www.pzh.gov.pl/zasady-postepowania-i-pobierania-materialu-do-badan-mikrobiologicznych-w-kierunku-legionelozy-choroby-legionistow-wykonywanych-w-celach-sanitarno-epidemiologicznych-w-nizp-pzh-pib/